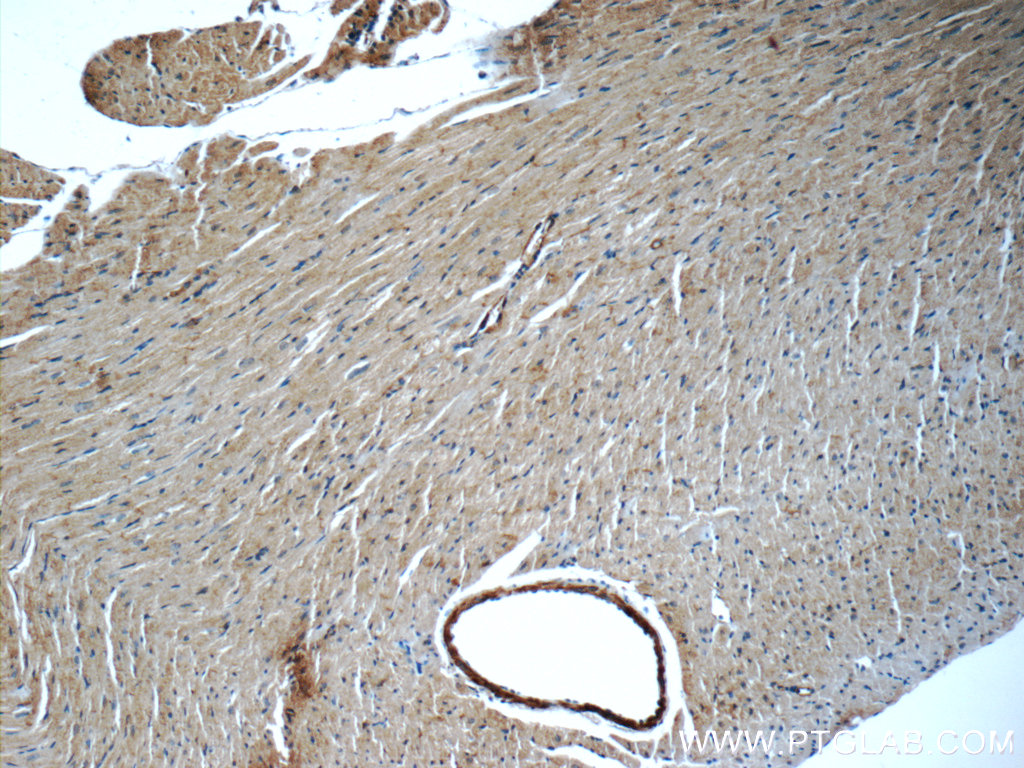

验证数据展示
经过测试的应用
| Positive WB detected in | NIH/3T3 cells, A431 cells, HEK-293 cells, HeLa cells, Jurkat cells, MCF-7 cells, RAW 264.7 cells, RAW264.7, SH-SY5Y cells |
| Positive IHC detected in | human prostate cancer tissue, human lung cancer tissue, mouse heart tissue Note: suggested antigen retrieval with TE buffer pH 9.0; (*) Alternatively, antigen retrieval may be performed with citrate buffer pH 6.0 |
| Positive IF/ICC detected in | HeLa cells |
推荐稀释比
| 应用 | 推荐稀释比 |
|---|---|
| Western Blot (WB) | WB : 1:500-1:3000 |
| Immunohistochemistry (IHC) | IHC : 1:50-1:500 |
| Immunofluorescence (IF)/ICC | IF/ICC : 1:200-1:800 |
| It is recommended that this reagent should be titrated in each testing system to obtain optimal results. | |
| Sample-dependent, Check data in validation data gallery. | |
发表文章中的应用
| WB | See 33 publications below |
| IHC | See 3 publications below |
产品信息
10023-1-AP targets JNK in WB, IHC, IF/ICC, ELISA applications and shows reactivity with human, mouse, rat samples.
| 经测试应用 | WB, IHC, IF/ICC, ELISA Application Description |
| 文献引用应用 | WB, IHC |
| 经测试反应性 | human, mouse, rat |
| 文献引用反应性 | human, mouse, rat |
| 免疫原 |
CatNo: Ag0019 Product name: Recombinant human JNK protein Source: e coli.-derived, PGEX-4T Tag: GST Domain: JNK of NM_138982 Sequence: 种属同源性预测 |
| 宿主/亚型 | Rabbit / IgG |
| 抗体类别 | Polyclonal |
| 产品类型 | Antibody |
| 全称 | mitogen-activated protein kinase 8 |
| 别名 | MAPK8, JNK1A2, JNK1, JNK 2, JNK 1 |
| 计算分子量 | 48 kDa |
| 观测分子量 | 40-45 kDa, 50-55 kDa |
| GenBank蛋白编号 | NM_138982 |
| 基因名称 | JNK |
| Gene ID (NCBI) | 5599 |
| RRID | AB_2281669 |
| 偶联类型 | Unconjugated |
| 形式 | Liquid |
| 纯化方式 | Antigen affinity purification |
| UNIPROT ID | P45983 |
| 储存缓冲液 | PBS with 0.02% sodium azide and 50% glycerol, pH 7.3. |
| 储存条件 | Store at -20°C. Stable for one year after shipment. Aliquoting is unnecessary for -20oC storage. |
背景介绍
Function
JNK1, also known as mitogen-activated protein kinase 8 - MAPK8, is a serine/threonine-protein kinase. It is an important player in signaling transduction pathways governing cellular response to external stimuli, including ultraviolet radiation (UV), inflammatory cytokines, and reactive oxygen species (ROS). JNK1 phosphorylates several transcription factors, such as c-Jun, Elk-1, and ATF2, affecting their transcription activity.
Tissue specificity
JNK1 is ubiquitously expressed.
Involvement in disease
JNK-mediated phosphorylation governs a variety of important cellular processes, and abnormalities of JNK1 activity have been implicated in obesity and cancer.
Isoforms
There are four isoforms of JNK1 (PMID: 8654373), giving rise to 46 kDa and 55 kDa isoforms. JNK1 isoforms differ in their substrate specificity and tissue expression profiles.
Post-translational modifications
JNK1 is phosphorylated by MAPK kinases (MAPKK).
Cellular localization
JNK1 is present both in the nucleus and in the cytoplasm. Stress conditions and other stimuli can cause a shift in JNK1 subcellular distribution.
实验方案
| Product Specific Protocols | |
|---|---|
| IF protocol for JNK antibody 10023-1-AP | Download protocol |
| IHC protocol for JNK antibody 10023-1-AP | Download protocol |
| WB protocol for JNK antibody 10023-1-AP | Download protocol |
| Standard Protocols | |
|---|---|
| Click here to view our Standard Protocols |
发表文章
| Species | Application | Title |
|---|---|---|
J Pineal Res Melatonin reprogramming of gut microbiota improves lipid dysmetabolism in high fat diet-fed mice. | ||
Front Oncol Upregulation of OTUD7B (Cezanne) Promotes Tumor Progression via AKT/VEGF Pathway in Lung Squamous Carcinoma and Adenocarcinoma. | ||
Neuropharmacology TRPC6-mediated ERK1/2 phosphorylation prevents dentate granule cell degeneration via inhibiting mitochondrial elongation. | ||
Ecotoxicol Environ Saf PM2.5 exposure induces reproductive injury through IRE1/JNK/autophagy signaling in male rats. | ||
J Biol Chem Inactivation of mouse transmembrane prolyl 4-hydroxylase increases blood brain barrier permeability and ischemia-induced cerebral neuroinflammation. | ||
Front Pharmacol BCATc inhibitor 2 ameliorated mitochondrial dysfunction and apoptosis in oleic acid-induced non-alcoholic fatty liver disease model |